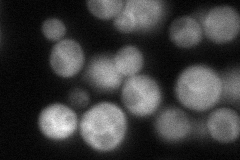
YBR263W

View description
Mitochondrial serine hydroxymethyltransferase, converts serine to glycine plus 5,10 methylenetetrahydrofolate; involved in generating precursors for purine, pyrimidine, amino acid, and lipid biosynthesis; reverse reaction generates serine
Localization:
Intensity:
Fold change:
Significance:
-
C’ GFP library in SD

mitochondria76.22 -
N' NOP1pr-GFP in SD

mitochondria268.37 -
N' TEF2pr-mCherry in SD

missing0 -
N' NATIVEpr-GFP in SD
cytosol108.373 -
N' TEF2pr-VC and Cyto-VN in SD

#N/A0 -
C’ GFP library in SD+DTT

mitochondria78.11.02No -
C’ GFP library in SD+H2O2

punctateN/AN/ANo -
C’ GFP library in Starvation Media

punctateN/AN/AYes -
C’ GFP library on the background of Pup2-DaMP

mitochondria -
C’ GFP library on the background of CCT mutant

mitochondria74.09880.972105No
